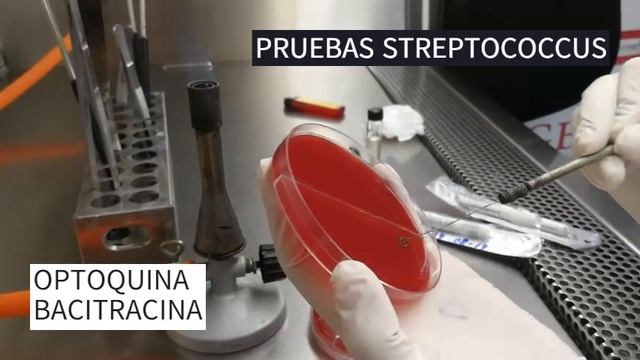
IDENTIFICACIÓN DE STREPTOCOCCUS Y ENTEROCOCCUS смотреть онлайн

Автор: Творческий Путь Страница 10

выдвижная розетка в столешницу купить алиэкспресс

Игра в карты)))

Обзор проекта Zeta Markets. Zeta Markets – полноценная биржа деривативов на Solana

ДЛЯ ЧЕГО ОПЫТНЫЕ АВТОМОБИЛИСТЫ ГЛУШАТ ДВИГАТЕЛЬ СРАЗУ

Лукоморье А С Пушкин Стих ВсеЯСветная грамота

Ротацыя на Рестор друида или как стать топ Рдру!Чясть 3

НИКОГДА НЕ ОПАЗДЫВАЙ НА УРОК— "Late for Class"

VLOG : как я снималась в рекламе)))

Влияние разгона процессора и ОЗУ на производительность в играх

Как заменить верхний порожек на гитаре? На примере PRS Custom 24.

Линзы, увеличители, окуляры, микроскопы.

Настройка открытия страницы в новом окне CMS.S3 от Мегагрупп.ру

Создание и применение дисконтной карты.
IDENTIFICACIÓN DE STREPTOCOCCUS Y ENTEROCOCCUS

Куда пойти работать начинающему программисту 1С. РГСУ

СДЕЛАЛ СЮРИКЕН ИЗ КАРТОНА! #тёмчик #knife #сюрикен #syriken #картон #темчик

Где брать виртуальные номера? Получаем виртуальный номер с сайта simsms.org

Как почистить телефон от ненужного невидимого мусора, и увеличить память

Собираем педаль Nutcracker Distortion

Вариант входа в Office 365 - ключ безопасности

23 мая народный праздник Симонов день. Именины Земли. Что нельзя делать. Народные приметы и традици

DIY Dress Form - Making a Custom-fit Mannequin from (mostly) Repurposed Materials!

Майнкрафт - Как сделать наушники? (How to make a Airpods in Minecraft?)

р. Ишайя Гиссер - Хайей Сара 1. Ищите женщину (24.10.2021)
За каждым успешным каналом стоит личность, идея и сотни часов кропотливого труда. Если вы здесь, значит, автор «Творческий Путь» уже сумел зацепить ваше внимание своим уникальным стилем или подачей. А мы на RUVIDEO позаботились о том, чтобы вы могли изучить весь архив его работ в максимально комфортных условиях — без лишней суеты и преград.
Почему за работами канала «Творческий Путь» так интересно наблюдать? Всё просто: это честный контент, который находит отклик в сердцах зрителей. На нашем ресурсе вы можете смотреть онлайн все видео любимого автора бесплатно и в хорошем качестве. Нам важно, чтобы вы видели каждую деталь и слышали каждый нюанс, поэтому мы используем только стабильные плееры из открытых источников Rutube.
Следите за новинками канала, пересматривайте старые шедевры и открывайте для себя новые грани творчества «Творческий Путь». Мы постоянно обновляем ленту, чтобы у вас под рукой всегда были самые свежие выпуски. Никаких сложных регистраций — только вы и творчество, которое вдохновляет. Приятного вам путешествия по миру авторского контента на RUVIDEO!
Видео взято из открытых источников Rutube. Если вы правообладатель, обратитесь к первоисточнику.